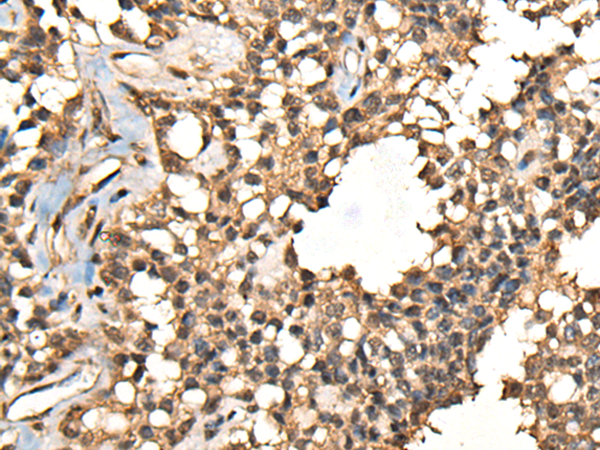

英文名稱: Anti-CASK rabbit polyclonal antibody
別 名: calcium/calmodulin dependent serine protein kinase; CMG; FGS4; LIN2; TNRC8; CAGH39; CAMGUK; MICPCH; MRXSNA
相關類別: 一抗
宿 主: Rabbit
技術規格
|
Background: |
This gene encodes a calcium/calmodulin-dependent serine protein kinase. The encoded protein is a MAGUK (membrane-associated guanylate kinase) protein family member. These proteins are scaffold proteins and the encoded protein is located at synapses in the brain. Mutations in this gene are associated with FG syndrome 4, mental retardation and microcephaly with pontine and cerebellar hypoplasia, and a form of X-linked mental retardation. Multiple transcript variants encoding different isoforms have been found for this gene. |
|
Applications: |
ELISA, IHC |
|
Name of antibody: |
CASK |
|
Immunogen: |
Fusion protein of human CASK |
|
Full name: |
calcium/calmodulin dependent serine protein kinase |
|
Synonyms: |
CMG; FGS4; LIN2; TNRC8; CAGH39; CAMGUK; MICPCH; MRXSNA |
|
SwissProt: |
O14936 |
|
ELISA Recommended dilution: |
5000-10000 |
|
IHC positive control: |
Human esophagus cancer and human ovarian cancer |
|
IHC Recommend dilution: |
50-300 |

購物車
購物車 幫助
幫助
 021-54845833/15800441009
021-54845833/15800441009
